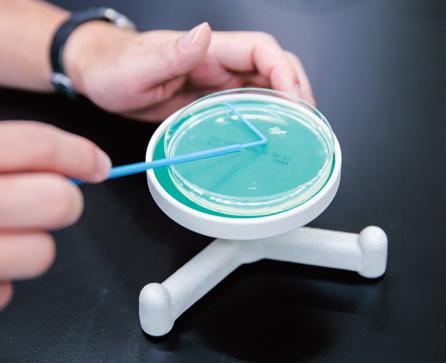
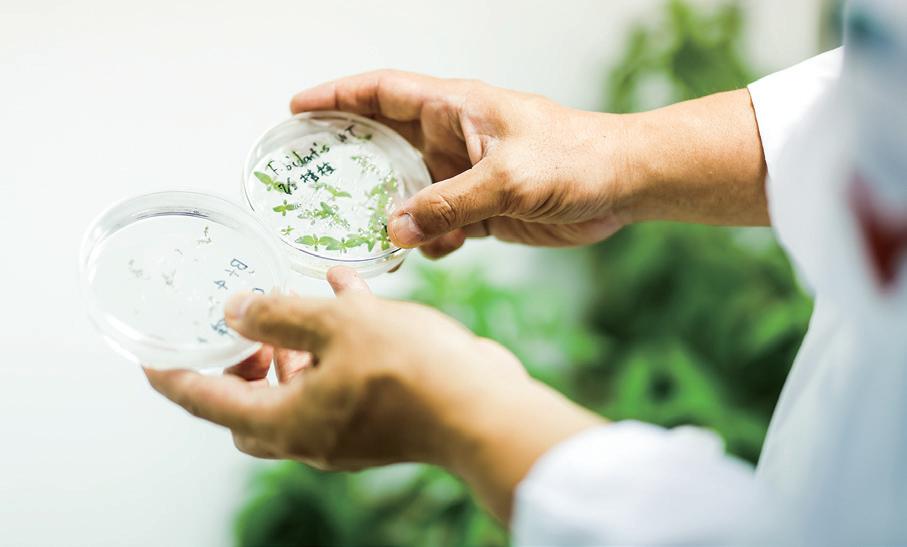

研究室315 (植物栄養学研究室/玉井鉄宗)
研究室314 (野菜園芸学研究室/滝澤理仁)
研究室313 (応用線虫学研究室/岩堀英晶)
研究室312 (作物学研究室/松村篤)
研究室311 (英文学・英語教育研究室/吉村征洋)
研究室310 (花卉園芸学研究室/神戸敏成)
研究室309 (植物育種学研究室/三柴啓一郎)
実験室304
研究室308 (応用昆虫学研究室/柴卓也)
研究室307 (植物病理学研究室/平山喜彦)
研究室306 (グリーンサステナビリティ研究室/大門弘幸)
実験室303
研究室305
( 英文学研究室/垣口由香 )
研究室304 (真宗学研究室/打本弘祐)
研究室303
研究室302 (収穫後生理学研究室/ウェンダコーンS.K.)
研究室301
(果樹園芸学研究室/尾形凡生)
実験室302
実験室301
ヒト代謝 実験室 > P13
P2実験室 > P14
実験室306 実験室308
実験室305 実験室307
学科事務室 (生命科学科・農学科)
顕微鏡室 > P15
植物 培養室 > P12
研究室320
研究室319 (植物ゲノム工学研究室/土岐精一)
研究室318 (生命データ科学研究室/小野木章雄)
研究室317
(共生微生物学研究室/阪中幹祥)
研究室316
(理科教育学・地質学研究室/多賀優)
研究室215
研究室214 (多細胞動態研究室/別役重之)
実験室206 > P16
研究室213 (植物遺伝学研究室/竹中祥太朗)
研究室212 (化学生態学研究室/塩尻かおり)
研究室211 (健康行動科学研究室/上田由喜子)
研究室210 (土壌学研究室/森泉美穂子)
研究室209 (雑草学研究室/三浦励一)
実験室204 > P16
研究室208 (臨床栄養学研究室/矢野真友美)
研究室207 (公衆栄養学研究室/谷口祐一)
研究室206 (小児保健栄養学研究室/楠 隆 )
研究室205
(データ数理研究室/鈴木太朗)
研究室204 (応用生化学研究室/山﨑正幸)
研究室203 (応用微生物学研究室/田邊公一)
研究室202
(食品素材利用学研究室/西澤果穂)
実験室202
実験室201
研究室201
(栄養教育学研究室/岡﨑史子)
研究用
ガラス温室 > P17
臨床栄養学 実習室 > P04
栄養教育 実習室 > P05
学科事務室 (食品栄養学科)
研究室106
研究室105
(病態栄養学研究室/山本泰三)
研究室104
(食品化学研究室/桝田哲哉)
研究室103
(食品生理学研究室/山崎英恵)
研究室102
(運動栄養学研究室/石原健吾)
研究室101
(給食経営管理学研究室/朝見祐也)
実験室102
実験室101
基礎
実験室1 > P07
基礎
実験室3 > P08
基礎
実験室4 > P08
動物飼育室 処置室 > P09
基礎
実験室2 > P07
農学部教務課
食品加工 実習室 > P06
調理学 実習室 > P06 オープン キッチン > P03
給食経営管理 実習室 > P03
実験室208
実験室205 実験室207
研究室219
研究室218 (環境生理学研究室/古本強)
研究室217
(線虫ゲノム科学研究室/浅水恵理香)
研究室216
研究室220 実験室203
低温室 > P11
機器 分析室 > P10
4号館 > P19
農学部牧農場(大津市牧地区) > P18
給食経営管理実習室
/オープンキッチン
給食施設における大量調理をシミュレーションできる 最新の厨房機器が設置された実習室
管理栄養士国家試験の受験資格取得に必須の 「給食経営管理実習」で使用。最先端の厨房機器 を用いて実際の給食をイメージした約100食分 の大量調理の実習を行います。つくった料理は、 隣接するオープンキッチンで教職員や学生に提 供し、給食運営を疑似体験できます。
実際の給食施設に近い環境下で
実践的かつ衛生的な調理技術を体得する
給食経営管理学研究室
食品栄養学科 教授 朝見 祐也
あらゆる調理法に対応したスチームコンベクションオーブン や食材の急速冷却が可能なブラストチラーなど最新の厨房調 理機器を導入しており、管理栄養士をめざす学生が最先端の給 食経営管理を学べます。学生たちは実際に約100食分の大量調 理を行い、併設されたオープンキッチンで提供もします。その 際、食事する学部生や教職員に料金を支払ってもらうのがポイ ント。学生自身が調理した食事の対価を受け取ることで、給食 管理において重要なコスト面を自然と意識するようになりま す。そして、赤字にならないように献立を工夫するなど、実際 の給食運営に役立つ技術や管理栄養士に必要な知識を実践的 に身につけます。大学院生は、フードサービス業界で提供され る食事の調理法を学ぶため、特に衛生管理に重点を置いた調理 実習を行います。農場から食卓に届くまでの衛生管理や流通方 法について理解を深めながら、衛生的な調理技術を体得できる のも、実際の給食施設さながらの設備が整っているこの実習室 ならではでしょう。おいしさはもちろん、衛生的かつ効率的な 食事提供を理解し、給食施設をマネジメントできる人材を多く 輩出したいと考えています。
臨床栄養学実習室
模擬病棟で栄養アセスメント・栄養指導を学び、 チーム医療で活躍できる管理栄養士に成長
病気をもった人の身体と栄養の関わりについて 学ぶための実習室です。医療ベッドや車いす、 内臓脂肪測定装置、脈波伝播速度測定装置、心 電図などを完備し、実際の病院を想定した本格 的な実習が行えます。
専門知識や多職種連携の方法を体験学修し、
人に寄り添う心も養う
食品栄養学科 講師 矢野 真友美 臨床栄養学研究室
管理栄養士はチーム医療の一員として、医師や看護師と共に 病棟を巡回して患者と直接触れ合います。臨床栄養学実習室 は、その際に必要なコミュニケーションスキルや心構え、ベッ ドサイドでの栄養アセスメント・栄養指導の方法、チーム医 療内での適切な提案手法などを実践的に学ぶための実習室で す。臨床現場で使用される設備を備え、プロの模擬患者によ る栄養指導演習も取り入れ、本番さながらの緊張感が漂う実 習を行います。機器は複数台用意され学生全員が滞りなく体 験可能。体脂肪測定キットや脈波伝播速度測定装置の扱い方、 血糖値検査データをはじめとした検査データの読み方などを 修得できます。また、心電図や胃ろうモデル、点滴シミュレー タなども完備。医師や看護師が行う医療行為や医療機器の目 的・意義、他職種の専門用語についても学び、チーム医療で活 躍するための素地を養います。さらに、特殊メガネや重りを 用いた高齢者疑似体験をはじめ、車いす体験や杖歩行体験も 実施します。高齢になると床のペンを拾うだけでも大変なこ とや、車いすでは少しの段差でも乗り越えられないことなど を体感し、患者に寄り添う心を育みます。
基礎実験室1・2
自らの手で実験や実習を体験し 3年生以降で履修する専門科目の基盤を確立する
フラスコやシャーレなど基本的な実験器具、顕 微鏡や解剖器具などの実験機器、最新の視聴覚 機器を備えており、2年生の学科基礎科目のう ち、主に食の安全に関する科目の学生実験・実 習に使います。科目の内容を実際に体験し、多 面的に理解するという意義があります。
じっくりと実験に取り組み
実験の原理に対する理解を深める
食品栄養学科 教授 田邊 公一 応用微生物学研究室
学生が実験に慣れ親しみ、実験の原理を理解することを目的 に、2年生の学科基礎科目で使用します。「微生物学実験」では、 滅菌操作や顕微鏡観察を通じて微生物の取り扱い方を学び、食 品に付着する微生物の菌種を調べて身近に存在する微生物へ の理解を深めます。「食品衛生学実験」では、インスタントラー メンやひき肉など普段から口にする食品を用いて、腐敗や添加 物に関する実験を行います。この施設は小規模で目が届きやす く、モニターを介さず実験操作の実演を間近でみられるため、 実験に不慣れな学生でも安心して学べます。また、顕微鏡や実 体顕微鏡が2人に1台用意されているなど実験機器が充実して おり、時間をかけてじっくり実験操作に取り組めるのも特長で す。プロジェクター関係の最新視聴覚機器は、コンピュータや カメラ、顕微鏡などの複数機器の同時接続が可能で、画面を切 り替えながら、効率よく授業がすすめられます。座学の授業と 連結すれば、より理解が深まるので、学生には座学と実験を並 行して受講するよう推奨しています。これらの科目は一般的な 理系学部の学修内容も含むため、管理栄養士以外の仕事にも役 立つ幅広い知見を得られます。
基礎実験室3・4
1度に100名以上での実習可能な設備機器を完備 助手のサポートのもと実験技術の基礎を学ぶ
植物などの個体レベルからタンパク質やDNAといった分子レ ベルまで、幅広い実習内容を網羅できる機器や器具が整備さ れ、多くの実験科目に対応しています。また2つの実験室にま
たがる大人数の実験でも指導が行き届くよう、教員の声やスラ イドが配信できる仕組みを完備。配置された助手のサポートを 受けながら、基礎的な実験技術や原理を学びます。
じっくりと実験に取り組み
実験の原理に対する理解を深める
線虫ゲノム科学研究室
生命科学科 教授 浅水 恵理香
生物観察および、分子生物学や細胞生物学実験に必要な機器が 整備された実習室で、植物の観察手法、ウイルスの観察技術、分 子生物学や細胞生物学の実験手法、データ解析技術などを学び ます。100名を超える実習でも指導が行き届くようにオーディ オや実験設備、多数の実験機器が完備されているため、全員が 同時に手を動かして実験を行えます。また、複数の助手が配置 されており、大人数の実習でもきめ細かな指導が可能。班員が 協力しながら実験する姿も見られ、楽しく実験に臨めるのも特 長です。基礎的な実験技術から、卒業研究で使用する実験手法 の手技や知識まで、幅広く修得できます。
病原菌の培養や観察を体験し、 卒業研究を行う基礎力を育む
植物病理学研究室
農学科 准教授 平山 喜彦
本施設では、PCRで線虫の種類を調べたり、植物組織や微生物 の培養を実施したりします。さらに、植物からのDNA抽出や微 生物の遺伝子組み換え操作なども実際に行います。私が担当す る実習では、植物の病気を引き起こす病原菌をテーマに、植物 病害の診断、病原菌の分離と培養、顕微鏡での観察と同定まで を体験。そのために必要な振とう機や恒温器、クリーンベンチ、 滅菌を行うオートクレーブ、光学顕微鏡なども完備されていま す。教員の手元を映すモニターを設置するなど学生の学びやす さにも配慮。本施設で幅広い実習を経験し、卒業研究の土台と なる知識と技術を身につけます。
低温室
4℃に保たれた部屋で、種子や土壌の保存、 サンプルの調整、低温化での実験を行う
低温室は基本的に4℃に保たれた部屋です。研 究や実習で使用される種子の保存や、室温では 行えないサンプル(試薬や土壌など)の調整・保 存、低温下での実験に利用されます。全部で3部 屋あり、それぞれ大きさは約5畳。目的にあわせ て使い分けられています。
3つの低温室を使い分け、
効率的かつ間違いのない研究が可能
応用生化学研究室
食品栄養学科 教授 山﨑 正幸
低温下では、一般的にさまざまな化学反応や生物成長のス ピードが遅くなるため、物質の変化や劣化を抑えられます。 その性質を利用すべく、室温を4℃に保った施設が低温室で す。まさに部屋を丸ごと冷蔵庫にしたような施設といえるで しょう。農学部では、低温室を3部屋設け、目的によって使い 分けています。一つは農学部牧農場でとれた作物や土壌のサ ンプルの保存、一つは種子の保存を行っています。そして、最 後の一つでは、生化学的なサンプルの保存、タンパク質の精 製といった低温下での実験作業を実施。4℃という室温は、タ ンパク質の精製を行うために使用するクロマトグラムが、サ ンプルの状態を安定に保ちつつ、最も性能を発揮できる温度 なのです。3部屋あるため、サンプルが混ざる危険性が下がる のはもちろん、異なる温度で使用できる点がメリットです。
実際に、種子の保存においては、湿度の上昇を避けるため、通 常の4℃ではなく、8℃で温度設定をしています。学生は、卒 業研究の際に低温室を活用します。試薬や種子、土壌といっ たサンプルを保管し、低温で行うべき実験を実施できる環境 が身近にあることで、本格的な研究を行えます。
植物培養室
人工的に制御したさまざまな環境下で植物栽培を行い、 育成条件の最適化などを行う
温度や湿度、光照射時間などをコントロールできる植物培養ユ ニットを設置した施設です。人工気象ユニットと高機能型人工 気象ユニットをあわせて28基以上あるのは全国の大学でも有数
の規模です。さまざまな環境下での植物栽培のシミュレーショ ンを行うことができ、人工栽培が難しいとされる植物の育成条 件の解明など、実際に成果をあげている研究も多数あります。
全国でも有数の規模の施設で、
実験者として基本姿勢を育む
環境生理学研究室
生命科学科 教授 古本 強
農学部の各研究室で実施される卒業研究などのための植物や 昆虫の育成と実験に使用します。遺伝子組み換え植物を育て ることも可能です。温度や湿度などを調節して実験に必要な 環境を自由につくり出せる人工気象ユニットが25基あり、高 輝度の光を必要とするイネなどの育成のための高機能型人工 気象ユニットも3基完備。大学としてこれほどの規模で施設 があるのは、全国的にも少なく、西日本では唯一ともいわれ ています。植物の育て方のほか、各教員が対象とする植物の 光量や温度などの物理的環境の変動への応答、食害昆虫や病 原微生物などの生物的な応答の様子を研究しています。まさ に先端研究を支えている施設といえるでしょう。学生は、実 験材料を丁寧に準備したり、遺伝子組み換え施設としての厳 格なルールを守って利用するなかで、実験者としての基本姿 勢を養えます。また、日々の植物の成長をみることで、ちょっ とした変化を見逃さない観察力が鍛えられます。観察力は、 問題解決の糸口を探るための重要な力です。研究はもちろん、 社会に出ていろいろな問題点に対応する際に、状況や対象を 正しく見極めるために活用できる力です。
最先端の顕微鏡や特殊な顕微鏡に触れ、 生物学の基本となる「観察」の基礎や原理を学ぶ
多彩な顕微鏡での観察をとおして 生命に関する理解を深める
多細胞動態研究室
生命科学科 教授 別役 重之
実体顕微鏡から共焦点顕微鏡まで最新機種を完備した施設で、 生物物理学実習や、卒業研究など各研究室での研究活動を行い ます。生物物理学実習では蛍光・共焦点顕微鏡を用いた蛍光イ メージングの原理と実践を学修します。各研究室では、より実 践的に植物や病害虫、細菌や酵母といった微生物、ヒトの培養 細胞など多彩な試料を、目的にあわせた多彩な手法で観察しま す。一つの試料を異なる顕微鏡で観察することで新たな気づき があり、生命に対する理解と探究心が深められます。また、共 焦点顕微鏡を従来より高速・高解像度のものにするなど、機器 を常にアップグレードしています。
倒立顕微鏡、蛍光顕微鏡、高解像ズーム顕微鏡、 共焦点レーザー顕微鏡といった各種顕微鏡や、 生体組織を薄く切るマイクロスライサー、タン パク質の構造を解析するX線結晶構造解析装置 などを完備。植物組織や微生物、細胞内の小器 官や染色体まで多彩な観察が可能です。
X線結晶構造解析装置を用いて タンパク質の構造・機能の研究を行う
食品化学研究室
食品栄養学科 教授 桝田 哲哉
タンパク質の立体構造を原子レベルで決定するX線結晶構造 解析装置を、農学部として完備しているのが本学の特長です。 学生は、タンパク質の結晶の生成からX線による測定、測定 データを用いての構造決定まで、研究の入口から出口まです べてを体験。繊細な結晶の取扱い方や最適なデータ取得の方 法など、X線結晶構造解析に関わるさまざまな技術と知識を、 実習をとおして身につけることができます。そして、新規食品 素材の開発や創薬をはじめ無限の可能性を持つタンパク質の 研究に触れながら、「ミクロな眼」で生命現象を化学的に理解 し、思考力を深めてほしいと考えています。
クラスター実験室
2つの研究室が共同で実験室を使うことで、 実験・研究の幅広い手法や考え方を学べる
教員や学生が自らの専門分野の研究を行う実験 室で全18室あります。2つの研究室が共同で使 用しています。マイクロピペッターや遠心機、 PCR装置をはじめ各研究のための設備・機器が 完備され、学生は専門的な実験・研究手法を学 修し、卒業研究を完成させます。
植物のDNA・遺伝子ついて実験・
解析しながら研究手法を身につける
植物ゲノム工学研究室
生命科学科 教授 土岐 精一
一般的な実験機器に加え、各実験のための特別な設備や機材も 用意しています。例えば、私たちが行う植物のDNA・遺伝子の 研究では、次世代シーケンサーやディープラーニング用計算機、 自動分注を行うロボット、メーカーと共同開発した独自のイン キュベーターなどを使用。学生はそれらの機器に実際に触れ、 遺伝子組み換えやDNAのデータ解析を行いながら、専門的な研 究の方法を学びます。クラスター実験室の特長は、2つの研究室 が共同で使用する点。実験室の垣根を越えた交流ができ、自分 たち以外の実験手法なども身近で感じられるため、研究者とし ての素養が高められます。
地道かつ工夫を凝らす分析・解析で
「見えないもの」を見る力を養う
土壌学研究室
農学科 教授 森泉 美穂子
土壌学研究室の学生は、クラスター実験室の化学発光分析計や TOC計、分光光度計などを用いた土壌の化学分析を軸に卒業研 究をすすめます。土壌の本質という目には見えないものを見る ために、分析データの解析方法や活用法を学ぶのはもちろん、 研究に必要な測定装置を工夫して自作したり、効率化を図るべ く機器の改善を行ったりもします。最近もみんなで団粒分析器 の自動化に成功しました。このように、時には数百点を超える サンプルの分析作業や、研究に対する創意工夫をとおして、実 験の基礎力と精神力を育みます。また、学生同士で協力して研 究をすすめるなかで絆と思い出が生まれる場所でもあります。
4 号館
Building No.4
文系と理系、両方あっておもしろい
食べものや農業に関する課題は、自然科学分野の研究だけでは解決できません。 それは、社会の仕組みや経済の動きと、深く関係しているからです。
食料農業システム学科では、食べものや農業に関する課題について、
社会や経済、地域や環境など、社会科学分野の視点から考え、 取り組むための学びを展開しています。
Floor Guide
※1階、地下1階のフロアマップは省略しています。
304 研究室 (東洋史学/ 遊牧文化研究 室/中田裕子)
335 大学院 共同研究室 > P22
研究室 (環境史・環 境社会学研究 室/渡邊洋之) 325 研究室 (食料・農業・ 環境経済学 研究室/竹歳 一紀)
303 研究室 (フードビジ ネス研究室/ 金子あき子)
302 研究室 (日本の食文 化研究室/ 尾崎智子)
301 研究室 (食文化・地域文化 研究室/落合雪野)
332 研究室 (農企業経営情報会計学 研究室/香川文庸)
331 演習室 学科事務室 (食料農業 システム学科)
小会議室
策・キャリア 教育研究室/ 佐藤龍子)
219 農学部 理科実験室 > P21
326 研究室 (地域マネジ メント・資源 保全研究室/ 中川千草)
327 研究室 (食・農資源 経済学研究室 /中川雅嗣)
328 研究室 (食農ビジネス 研究室/淡路和則)
演習室
理論学修・資料調査からディスカッションまで行い 社会科学的視点で農を探求する
経済学や経営学、社会学などの基礎理論を学 んだり、統計資料を分析したり、現地実態調査 の準備や振り返り学修、学生同士のディスカッ ションを行ったりします。戦後間もない時期の 貴重な資料をはじめ、全国各地から多彩な統計 資料が収集・保管されているのも特長です。
ゼミをとおして、食や農を
社会科学的に分析する術を身につける
環境史・環境社会学研究室
食料農業システム学科 准教授
渡邊 洋之
大学におけるゼミとは一般に、教員の指導のもと、指定され たテーマや書籍の内容について、少人数の学生が自ら発表し て討論する授業形態を指します。これだけでなく、このゼミ のメンバーによるさまざまな取り組みも、ゼミの活動に含め たりします。食料農業システム学科では、このゼミ活動を中 心に専門教育がなされており、専門教育を担当する教員がそ れぞれ、卒業論文にいたるまでのさまざまな学びを提供する ゼミを開講しています。また教員は、4号館3階に一つずつ演 習室をもっていて、各ゼミ所属の学生は、3年生から週に1回 はこの演習室に集うことになります。ただしゼミでの活動は、 教員一人ひとりで違いがあります。私のゼミのように、聞き 取り調査など社会科学の基本的技法について、演習室で徹底 的に学ぶゼミもあれば、実際に農業の現場に何度も足を運び、 地域の方々と共にプロジェクトを実施していくようなゼミも あります。なお演習室は、毎週のゼミでのみ使われるわけで はありません。演習室はゼミ所属の学生に開放されているの で、ゼミ生同士の話し合いの場として、または各々が自習す る場としても使われています。
農学部理科実験室
グループワーク用可動式ホワイトボード、物理教材や各種標本も 完備し「教える力」を伸ばす主体的な学修や実験が可能
物理分野と地学分野に特化した多彩な実験を行える施設です。 ホワイトボードやプロジェクター、小グループワークに適した 多数の可動式ホワイトボードを完備。三葉虫をはじめとした化
石類や鉱物類、岩石類の標本も充実しています。「地学実験」や 「物理学実験」などの授業をはじめ、教員免許状更新講習や教 員向けの研修会・講座などでも使用します。
物理と地学の実験を通じ
理科の教員免許状取得に向けた学びを行う
理科教育学・地質学研究室
農学科 教授 多賀 優
砂や泥が下水に流れていかない流し台を設置するなど、物理分 野と地学分野の実験が行えるように設計された施設です。グ ループワーク用可動式ホワイトボードなど講義を円滑にすすめ る設備も完備しています。理科実験室で行う「地学実験」では、 地学に関する知識や実験技術を学ぶだけでなく、理科の先生と して、子どもたちに地学の魅力を伝えるための手法や心構えを 養います。また「物理学実験」では、実験の前に学生が必ず予想 を立てる「仮説実験授業」を導入。学生の考えや意見を中心に 組み立てた授業で、思考力を磨きます。これらの学びにより、 小学校や中学校、高等学校で授業を運営する方法や教師として の話し方、児童・生徒の理科に対する興味・関心をかき立てる 指導力なども身につきます。実際に理科の先生として活躍する 卒業生も多くおり、農学部理科実験室での実践的な学びを現場 で活かしています。物理実験の教材や化石類、鉱物類、岩石類 の標本など、充実している点も特長の一つ。さらに、教員免許 状更新講習や教員向けの研修会などにも農学部理科実験室は使 用されます。現役の教師が研修を行うほどに充実した施設で、 教員志望の学生は模擬授業の練習を行うこともできます。
Fieldwork
学外ゼミ活動
食料生産者を訪ね、話を聞き、仲間と議論を重ねて、
社会課題への柔軟な思考力を養う
食料農業システム学科(地域マネジメント・資源保全研究室)准教授 中川 千草
学外ゼミ活動は、「現場のリアリティの探究」として位置づけられるものです。食料生産を生業 とする方々の元を訪問し、生産者目線の工夫や抱えておられる課題についてお話を伺ったり、 種まきや収穫といった作業に参加させてもらったりすることで、学内での学びを深めることが できます。中川ゼミのテーマは、環境 ・観光 ・食の観点から、地域資源の持続可能性や地域づく りについて考えること。例えば、京都市内の有機農産物の生産・卸企業では、環境や資源の持続 性と、流通販路の確保や拡大といったビジネスとしての確実性との両立をめざした農業のあり 方について学修。また、丹波篠山市では、黒豆、山の芋などの農産物の収穫体験や直売所の見学、 獣害問題や都市部からの移住についてのインタビューをとおして、新規就農の可能性や魅力を 知ると同時に、きれいごとでは済まない農業の現実を知ることができました。このように学外 ゼミ活動は、現場に生きる方々の思いや経験を直接聞かせてもらうことで、さまざまな社会、環 境の問題を自分の問題として考える機会につながっています。このような経験は、幅広く柔軟な 思考を身につけることの礎となります。また、学生同士や現場の方々とのコミュニケーション から、社会はさまざまな人々の集合体であり、「答えは一つではない」ということを実感し、意 見の違いをポジティブに捉え、建設的な講論が生まれることが期待できます。学外ゼミ活動は、 新たな知識や情報を得る機会として、また「自分の当たり前」を見直す機会として、学生生活を より豊かなものにしてくれます。こうした経験は、社会に出た後、協働の可能性を信じ行動でき る力を養うことにつながるものだといえます。
学外ゼミ活動
地域の農業資源を活かした地域ブランド商品の開発や
都市農村交流イベントの開催に貢献
食料農業システム学科(フードシステム学研究室)准教授 山口 道利
私たちのゼミでは、滋賀県随一の柿の産地である高島市今津町深清水の地域活性化に取り組んでいま す。そのなかで、栽培放棄園の活用策としてオリーブ栽培をすすめている高島深清水オリーブ産地協議 会と連携協定を締結し、「しがのふるさと支え合いプロジェクト」などの滋賀県のプロジェクトのもと で、オリーブの産地化をめざした活動も行っています。これまで学生たちは、都市農村交流イベント(柿 祭り、高島ロングライド)のサポートやオリーブの植樹、オリーブ茶の商品化に向けたパッケージデザ インなどを実施。2021年6月には、オリーブ茶の販売が実現しました。この商品販売の実現をきっかけ に、現地では豊富な地域資源を商品化しようとする取り組みが進行しています。今後もゼミの活動とし て、柿やオリーブをはじめとする深清水の地域農業資源を活かした地域ブランド商品の開発をサポー トしていく予定です。このように、学生たちは現地を直接訪れ、地域を自分の目で見て、自分の足で歩 いて感じ、現地で暮らす方々と対話を重ね、実際にプロジェクトに参加。それにより、生産現場から流 通・消費に至るまでのフードシステムの課題をとらえ、その解決方法についても深く考えていきます。 そして、地域の生産者や販売業者、県の関係者など多彩な主体を巻き込みながら当事者の一人としてプ ロジェクトをすすめるなかで、「話を聴く力」や「感じる力」、冷静な分析力や調べる力をはじめとした 「考える力」が養われます。同時に、地域において新しい取り組みや連携が広がっていく様子を目の当 たりにすることで、学修のモチベーションが高まり、地域に関わる仕事への関心も向上します。まさに、 社会全体が学びの場といえます。
龍谷大学のブランドストーリー
世界は驚くべきスピードでその姿を変え、 将来の予測が難しい時代となっています。
いま必要なことは、「学び」を深めること。
「つながり」に目覚めること。
龍谷大学は「まごころある市民」を育んでいきます。
自らを見つめ直し、他者への思いやりを発動する。
自分だけでなく他の誰かの安らぎのために行動する。 それが、私たちが大切にしている 「自省利他」であり、「まごころ」です。
その心があれば、激しい変化の中でも本質を見極め、 変革への一歩を踏み出すことができるはず。
探究心が沸き上がる喜びを原動力に、 より良い社会を構築するために。
新しい価値を創造するために。
私たちは、大学を「心」と「知」と「行動」の拠点として、 地球規模で広がる課題に立ち向かいます。 1639年の創立以来、貫いてきた進取の精神、 そして日々積み上げる学びをもとに、様々な人と手を携えながら、 誠実に地域や社会の発展に力を尽くしていきます。
豊かな多様性の中で、心と心がつながる。人と人が支え合う。
その先に、社会の新しい可能性が生まれていく。
龍谷大学が動く。未来が輝く。
You, Unlimited
龍谷大学 農学部
あらゆる「壁」や「違い」を乗り越えるために、「まごころ」を持ち、 「人間・社会・自然」について深く考える人を育む。
それが、龍谷大学の教育のあり方です。
自分自身を省み、人の痛みに感応して、 他者を受け容れ理解する力を持つ。
人類が直面するリアルな課題と真摯に向き合う。
そして様々な学びを通じて本質を見極める目を養い、 自らの可能性を広げていきます。
大津市瀬田大江町横谷1-5
瀬田キャンパス
大阪、京都、兵庫
から好アクセス
Tel 077-599-5601
agr@ad.ryukoku.ac.jp
JR京都駅 ー JR「瀬田」駅 17分
JR大阪駅 ー JR「瀬田」駅 45分
JR天王寺駅 ー JR「瀬田」駅 61分
JR三ノ宮駅 ー JR「瀬田」駅 67分
https://www.agr.ryukoku.ac.jp/